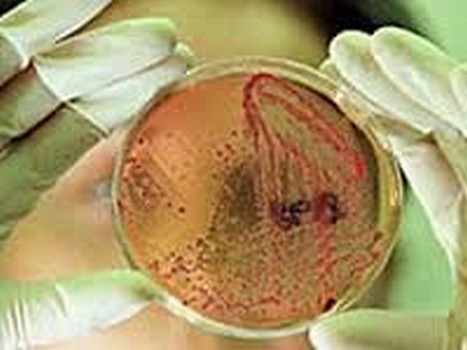
kirgiz_37

В Киргизии 37 тыс жителей Ак-Суйского района Иссык-Кульской области прошли медобследование в связи с тем, что в этом районе на прошлой неделе был обнаружен очаг бубонной чумы, от которой скончался подросток.
Как сообщает Argumentiru.com, в районе очага введен карантинный режим, дороги перекрыты.
Сотрудники МЧС и медики обходят каждый дом в зоне риска, на данный момент обследована почти половина — 7 тысяч дворов. Предположительно контактировавшие с умершим мальчиком 160 жителей района срочно госпитализированы.
«Поздно вечером накануне в инфекционное отделение госпитализированы еще 4 жителя села Ичке-Жергез с жалобами на повышение температуры. Все четверо в контакте с больным не были. Их анализы отправлены в департамент госсанэпиднадзора и в настоящий момент находятся в работе», — сообщила представитель пресс-центра минздрава республики Елена Баялинова.
Между тем, РИА Новости отмечает, что санитарные службы Киргизии осуществляют массовый отлов и уничтожение грызунов в рамках противоэпидемических мероприятий сообщила журналистам министр здравоохранения Киргизии Динара Сагинбаева.
В населенных пунктах района выставлены карантинные посты. Госсанэпиднадзор разбронировал 200 доз вакцины для профилактики чумы. Министр категорически опровергла возможность возникновения эпидемии чумы в республике.
«Я могу со всей уверенностью сказать, что эпидемии бубонной чумы не будет. Это локальная вспышка, все мероприятия проводятся в соответствии с международными стандартами», — сказала она.
Всего на территории Киргизии имеется 3 природно-очаговых зоны возникновения чумы, в том числе в высокогорных районах Иссык-Кульской области.
Предыдущий случай заболевания человека чумой в Киргизии был зафиксирован 32 года назад.